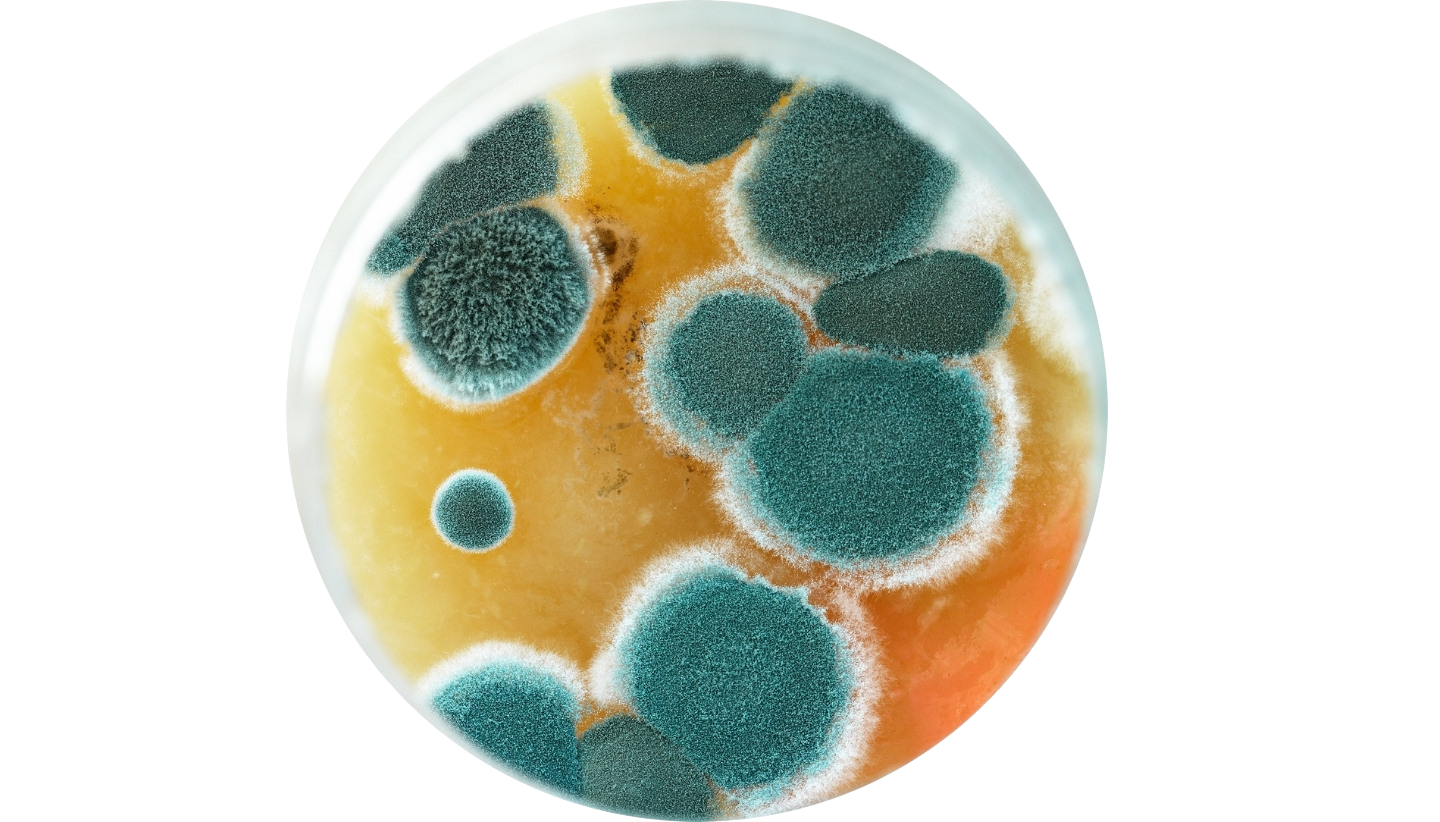

Professional Vehicle Disinfection
By Industry Expert
- Professional-grade disinfection for cars
- COVID-19 disinfection treatments
- Car odour removal
- Eliminates bacteria and viruses
- Safe and effective for daily-use and commercial vehicles
General Automotive Disinfection
One thing you’ll notice when you buy a used vehicle is the smell. Sometimes, this is a natural phenomenon, while other times, it is due to the uncleanliness of the previous users or the presence of biohazard contaminants such as pet urine, vomit, and spills. Research shows that an average car can harbour almost a million different types of harmful bacteria.
Envico provides vehicle disinfection for cars, vans, lorries, and buses—removing odours and contaminants for a fresher, healthier drive.
Eliminate the Invisible Enemies
Conventional cleaning and car disinfection methods may miss out on many blind spots or environmental parameters due to the microscopic size of germs, bacteria, and viruses. To address this, our team will utilise a machine specifically designed to target airborne viruses and those hiding inside the air-conditioning system of your car during the disinfection process.
Breathe cleaner air every time you drive.

Bacteria: 0.3μm – 30μm
Sources: Toilet, Kitchen/
Pantry, High touch surfaces
Mold Spores: 0.3μm – 30μm
Sources: Survives under
contaminated environment

Pollen: 10um – 100um
Sources: Outdoor/ Indoor
Plants, grasses, trees, flowers
and weeds

Dust: 1um – 100um
Sources: Clothes, upholstery,
carpet,pets, feather pillows,
and vents
Types of Transport Disinfection We Offer
- Marine vessel disinfection
- Food truck disinfection
- Car and commercial vehicle disinfection
Key Benefits of Envico Vehicle Disinfection
- Removes harmful germs, bacteria, and viruses
- Neutralises odours from food, pets, or smoke
- Improves air quality inside vehicles
- Targets hidden contaminants in AC systems
- Suitable for private cars, fleets, and commercial transport
- Creates a safer environment for drivers and passengers
Additional Services for Optimal Results
Vehicle Disinfection Specialist You Can Trust
Envico will take care of your vehicle disinfection just about anywhere in the area, maintaining the cleanliness of your property.
From family cars to commercial fleets, our trusted disinfection process helps protect everyone on board. Drive with confidence and peace of mind.
Get In Touch With Us
Please do not hesitate to contact us if you have any enquiry. Leave us a message and we will get back to you shortly.



